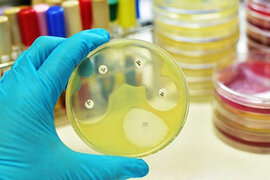
.

Xəbərlər
Qripin simptomlarının aradan qaldırmağın asan yolları
Qrip və kəskin respirator virus infeksiyasının simptomlarını aradan qaldırmaq üçün çoxlu maye içmək lazımdır. Trend-ə istinadən bildirir ki, mütəxəssi belə bir qənaətə apardıqlıar araşdırmadan sonra gəliblər. Belə ki, soyuqdəym
Sarımsaq damarları xolesterindən təmizləyir
Kaliforniya Universitetinin alimləri araşdırmalar nəticəsində aşkar ediblər ki, sarımsaq ekstarktı damarları xolesterindən təmizləyir və ürək xəstəliklərinin inkişafının riskini azaldır. Xolesterin (yağa oxşayan maddə) qa
Bu ürək xəstəliklərinin riskini 7 dəfə azaldır
Tanınmış kardioxirurq, akademik Leo Bokeriya (Rusiya Federasiyası) "Komsomolskya pravda" qəzetinin müxbirinə hər gün yarım saat ərzində açıq havada gəzməyin inanılmaz faydaları haqqında danışıb. Alim qeyd edib ki
Kök uşaqların sayı artır
Ümumdünya Səhiyyə Təşkilatının (ÜST) məlumatına görə ildən ilə bütün dünyada piylənmədən əziyyət çəkən uşaqların sayı artır. ÜST xəbər verir ki, dünyada ən azı 41 milyon 5 yaşına qədər olan uşaqlarda artıq çəki və piylənm
Bu qidalar qlaukomanın riskini 30% azaldır
Qlaukoma çox yayılmış göz xəstəliyidir. Xəstəlik adətən 40 yaşından sonra inkişaf edir. Qlaukoma bütün dünyada bərpa olunmaz korluğun əsas səbəbidir. Xəstəliyin əsas təhlükəsi gizli şəkildə inkişaf etməsidir. MedicalDail
Ana südü əsasında yeni antibiotik hazırlanıb
İngiltərə alimləri ana südünə daxil olan laktoferrin zülalının əsasında antibiotik hazırlayıblar. The Guardian xəbər verir ki, alimlər bu zülalın mikrobəleyhinə xüsusiyyətini araşdırıblar. Laktoferrin bakteriyaları, göbələklər

Kinkan dəmləməsi. Təbii müalicəvi vasitə
Kinkan çox faydalı meyvədir. Kinkan geniş profilaktik və müalicəvi xüsusiyyətlərə malikdir:. - vitamin və minerallarla olduqca zəngindir, soyuq fəsillərdə orqanizmi lazım olan maddələrlə təmin edir. - iltihabları azaldır

Qeyri-adi xəstəlik SÜRƏTLƏ YAYILIR: soyuq əşyaya belə reaksiya verir
Dünyada qeyri-adi xəstəlik - soyuğa qarşı allergiya daha tez-tez yayılmağa başlayıb. -a istinadən xəbər verir ki, bunu Moskva 52 saylı Şəhər Klinik Xəstəxanasının Şəhər Allerqologiya və İmmunologiya Mərkəzinin mütəxəssis

İmmuniteti möhkəmləndirən qədim hind MASALA çayı. RESEPT
Bu çay güclü iltihab, virus və mikrobəleyhinə təsirə malikdir, immuniteti möhkəmləndirir, orqanizmin infeksiyalara qarşı davamlılığını artırır. bildirir ki, alimlər Hindistanın məşhur Masala çayını virus və soyuqdəymə xəstəliklərini

Hamiləliyin ağır fəsadının inkişafını 1 həftə əvvəl bilmək olar
Statistikaya görə, hamiləliyin axırıncı üçaylığında 2-5% qadınlarda ağır fəsad olan preeklampsiya inkişaf edir. Preeklampsiyanın ağır formalarında qadında beyin qan dövranı kəskin pozulur ki, nəticədə qadın və körpə həla

İmmuniteti möhkəmləndiririk. 6 sadə məsləhət
İnsanın immun sistemi mükəmməl bir sistemdir. Güclü immunitet insanı istənilən xəstəlikdən qoruya bilər. Hər gün insanın orqanizminə hava, su, qida ilə milyonlarla müxtəlif mikroblar, viruslar, göbələklər daxil olur. İmmu

Uşağınız gec yatırsa
Yəqin, çox az valideyn tapılar ki, bu problemlə üzləşməsin. Çünki əksər ailələrdə yuxu rejimi ilə bağlı valideynlərlə uşaqlar arasında anlaşılmazlıqlar baş verir. Xüsusilə də, axşamlar günün yorğunluğundan xilas olmaq istəyə

Hansı qidalar qanda xolesterinin səviyyəsini aşağı salır?
Xolesterin insan orqanizmi üçün həyati vacib olan maddədir. Xolesterin bütün hüceyrələrin qışalarına (membran), sinir toxumasına daxildir, xolesterin bir çox hormonların sintezi üçün lazımdır. Bu səbəbdən xolesterini "ziyanlı"

Ürək döyüntülərinin artması zamanı XALQ TƏBABƏTİ vasitələri
Ürəyin bir dəqiqə ərzindəki döyüntülərinin sayı nəbz adlanır. Nəbz yaş, bədən çəkisi, fiziki quruluş, cins kimi bir sıra amillərdən asılı olaraq dəyişir. Ürək döyüntülərinin sayının 90-dan yuxarı qalxması taxikardiya adlanır

Qulunc olma – çarəsi
Yəqin ki, hamı başa düşər qulunc olma nə deməkdir və bəzi insanlar daha tez-tez qulunc olur və bundan əziyyət çəkirlər. Kimlər və niyə qulunc olurlar?. Daha çox oturaq həyat keçirənlər də (sürücülər, kompüter qarşısında ço

Asqırmanı saxlamaq TƏHLÜKƏLİDİR
Asqırmaq insanın özündən asılı olmadan baş verən baş verən bir prosesdir. Onun qarşısını almaq isə mümkün deyil. Asqırmaq bəzi xəstəliklərin əlaməti olmaqla yanaşı, həm də ətrafa mikroblar ötürür. Ancaq asqırmaqla bağlı alimləri

Dərinizin vəziyyəti pisləşibsə - bağırsaqlarınızı təmizləyin
Bir çox daxili xəstəliklər insanın üz dərisinin vəziyyətinə təsir edir. Təcrübəli həkim insanın dərisinə baxıb onun sağlamlığı haqqında bir çox şey deyə bilər. Belə ki, insanın bağırsaqları pis işləyirsə, onun üz dərisi he

Badam südü. İmmuniteti gücləndirən, öskürəyi sağaldan içki
Badam bir çox vitamin və minerallarla zəngindir. Badam südü bizə Hindistandan gəlib. Orada bu süd qədim zamanlardan çox təsirli müalicəvi və profilaktik vasitə kimi istifadə olunur. Badam südünün faydaları:. - ürək-dama

Reflüks xəstəliyi xərçəngin riskini artırır
Reflüks mədədən qida borusuna turş tərkibli mədə möhtəviyyatının atılmasıdır. Gün ərzində hər bir insanda orta hesabla 8-10 dəfə reflüks baş verə bilər. Bu normal sayılır. Davamlı xarakter alan reflüks zamanı isə mədəd

Pediatrdan xəbərdarlıq: O cür öskürən uşaq xəstəxanada yatmalıdır
Son zamanlar uşaqlar arasında öskürək, ürəkbulanma, qızdırma halları çox artıb. Hətta uşaq müalicə olunsa belə, xəstəlik tamamilə sağalmır, mütəmadi olaraq təkrarlanır. Uşaqlarda daimi burun axması, öskürək müşahidə olunur

Ədviyyatlar əsasında təbii məlhəm. Əzələ ağrılarına son
Qədim zamanlarda Şərqdə bir çox xəstəlikləri ədviyyatların köməyi ilə müalicə edirdilər. Xardal soyuqdəymə, cirə öskürək zamanı, keşniş toxumu sakiləşdirici kimi istifadə olunurdu və s. Qədim təbiblər soyuqdəymə, gərginlikl

Yeni işə gedənlərə bir neçə tövsiyə
Bazar ertəsi yeni işə çıxırsınız? Həyəcan və təşviş içindəsiniz? Yeni kollektiv, yeni insanlar, yeni iş rejimi və s. Bütün bu yeniliklərə necə uyğunlaşacağınızı düşünürsünüz? Biz sizə bununla əlaqədar bir neçə tövsiyyə təqdi

İnsultun inkişafını qabaqcadan bilmək mümkün olacaq. Yeni metodika
İnsult bir çox hallarda əlilliyə və ölümə səbəb olan ağır pozulmadır. Hal hazırda həkimlər insultun xeyli "cavanlaşmasını" müşahidə edirlər. Oksford Universitetinin alimləri insultun inkişafını qabaqcadan bilmə

Ədviyatlı çayla soyuqdəymədən qorunun
Havaların soyuduğu ərəfədə qrip ən çox rast gəlinən xəstəlikdir. Bunun üçün də orqanizmi sağlam tutmağa, virusdan qorunmağa çalışmaq lazımdır. Ədviyyatlar güclü mikrob, virus və iltihab əleyhinə təsirə malikdir. Axşam.az-

Qadınları orqazma çatdıran 7 seks pozası
Əkiz uşaq doğmaq üçün MÜTLƏQ OXUYUN
Yuxuda nar görmək görün nələrə işarə edirmiş?! İNANILMAZ!
Yeməyi bir dəfədən çox qızdırmağın sağlamlıq üçün TƏHLÜKƏSİ
Hər gün daha çox darıxıram' - Oqtay Əliyevi andı
Çak Norris vəfat etdi
Hər gün darçınlı su içsəniz
Qoz, badam və püstə qarşı-qarşıya: Budur ən faydalı çərəz
Dərmansız iki həftəyə yuxunu yaxşılaşdırmaq mümkün olacaq
Dilarə Kazımova ölkə üzrə top 10-a daxil oldu
Abbas Bağırov buna görə Gəncəyə köçüb
Hollivud ulduzu təhlükəli ərazidən çıxarıldı - Fotolar
Hamiləlikdə Daun sindromu riskini azalda bilən məhsul açıqlandı
Çox təhlükəli VİRUS: Yeni karantin qapıda